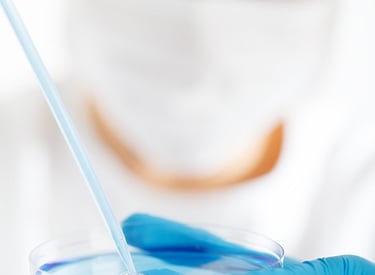

Nuestros servicios
Control microbiológico y calidad del agua para tu seguridad.
Evaluación inicial


Identificamos riesgos para prevenir contaminaciones desde el inicio.


Análisis microbiológico
Analizamos las muestras en la Unidad de Control Microbiológico o en el laboratorio colaborador, dependiendo de las necesidades.
Informes técnicos claros para seguimiento y toma de decisiones.
Informes y seguimiento
Proyectos
Control microbiológico entornos seguros.


Evaluación
Análisis inicial del riesgo sanitario.

Muestreo
Toma periódica de muestras de agua.




Análisis
Pruebas en sitio y en laboratorio.
Seguimiento
Monitoreo continuo y reportes.
→
→
→
→


Galería
Momentos clave del control y análisis microbiológico.






